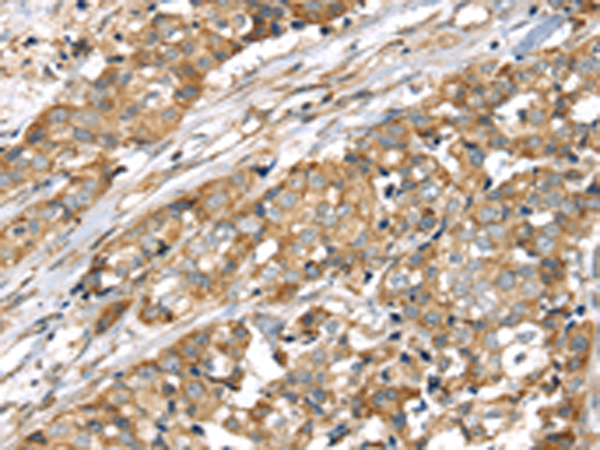
一抗

|
Background: |
This gene encodes a mitochondrial matrix protein that belongs to the Lon family of ATP-dependent proteases. This protein mediates the selective degradation of misfolded, unassembled or oxidatively damaged polypeptides in the mitochondrial matrix. It may also have a chaperone function in the assembly of inner membrane protein complexes, and participate in the regulation of mitochondrial gene expression and maintenance of the integrity of the mitochondrial genome. |
|
Applications: |
ELISA, WB, IHC |
|
Name of antibody: |
LONP1 |
|
Immunogen: |
Synthetic peptide of humanLONP1 |
|
Full name: |
lon peptidase 1, mitochondrial |
|
Synonyms: |
LON; LONP; PIM1; hLON; LonHS; PRSS15 |
|
SwissProt: |
P36776 |
|
ELISA Recommended dilution: |
2000-5000 |
|
IHC positive control: |
Human breast cancer and Human esophagus cancer |
|
IHC Recommend dilution: |
25-100 |
|
WB Predicted band size: |
106 kDa |
|
WB Positive control: |
A431, NIH/3T3 and HepG2 cells, Mouse liver tissue and Hela cells |
|
WB Recommended dilution: |
500-2000 |


 購(gòu)物車
購(gòu)物車 幫助
幫助
 021-54845833/15800441009
021-54845833/15800441009